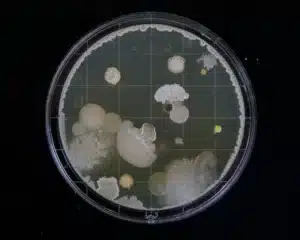
bilder till hemsidan 6

Mögelexperten Sverige AB
Trygga lösningar inom sanering, avfuktning, isolering och ventilation

Mögelexperten
Våra tjänster
Vi erbjuder allt från besiktningar till mögelsanering och avancerade ventilationssystem

Besiktning
Noggrann kontroll av fukt, mögel och inomhusmiljö för att identifiera eventuella problem.

Sanering

Ventilation
Installation av ventilationssystem för bättre luftkvalitet och minskad risk för mögeltillväxt.

Isolering

Avfuktning
Installation av avfuktare vid höga fuktvärden i krypgrunden eller på viden för att skapa en trygg miljö.
Mögelanalys
Provtagning och analys i oberoende laboratorium för att säkerställa omfattning och typ av påväxt.
1. Hög kundnöjdhet
Vi värnar om våra kunder och deras upplevelse. Därför ser vi alltid till att möta kunderna efter behov och situation. Det leder till stor kundnöjdhet som du kan läsa mer om under omdömen.
2. Specialkompetens
Med stor erfarenhet och hög kompetens identifierar vi orsaken till problemet och föreslår rätt åtgärd. Vi använder beprövade metoder och arbetssätt för trygga, långsiktiga lösningar.
3. Trygghet
Vi vet att fukt- och mögelproblem kan skapa oro. Därför prioriterar vi snabb återkoppling och tydlig uppföljning för att säkerställa er trygghet. Därför säkerställer vi alltid hållbara helhetslösningar.
4. Ledande samarbeten
Vi samarbetar med några av branschens största företag. Det innebär kvalitet, expertis och beprövade metoder för varje uppdrag.
Läs om våra kunders upplevelser
Omdömen


Vi svarar så snart som möjligt
Kontakta oss redan idag!
Om du exempelvis upplever problem med din inomhusmiljö, en konstig lukt eller misstänker mögel – hör av dig till oss, så svarar vi så snart som möjligt!






